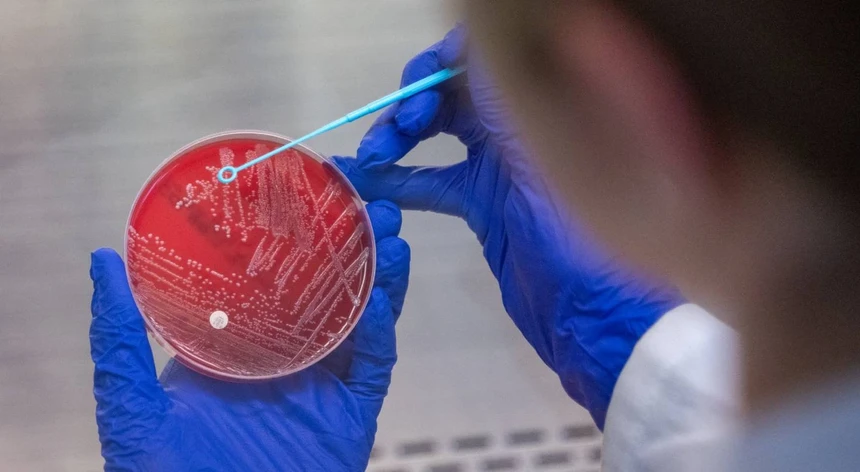

Resistência aos antibióticos mata 35 mil pessoas por ano
Mais de 35 mil pessoas morrem anualmente devido a infeções resistentes aos antibióticos, estimou hoje o Centro Europeu de Prevenção e Controlo de Doenças (ECDC), alertando que a resistência antimicrobiana continua a aumentar na Europa.
"Estima-se que as infeções resistentes aos antimicrobianos causem mais de 35.000 mortes por ano na UE/EEE [União Europeia e Espaço Económico Europeu], representando um encargo substancial para os indivíduos, as sociedades e os sistemas de saúde", adiantou o ECDC num comunicado que assinala o Dia Europeu da Consciencialização sobre os Antibióticos.
Segundo o centro europeu, o aumento da resistência antimicrobiana registado em vários países mostra que a "Europa não está no bom caminho" para atingir quatro das cinco metas estabelecidas para 2030 nesta área.
Desde 2019, a incidência estimada de infeções da corrente sanguínea causadas pela bactéria Klebsiella pneumoniae resistente à classe de antibióticos carbapenemes aumentou mais de 60%, apesar da meta de redução de 5% até 2030.
Da mesma forma, as infeções causadas pela Escherichia coli resistente às cefalosporinas de terceira geração aumentaram mais de 5%, contrariando o objetivo de uma redução de 10%, alertou o ECDC, avisando que o consumo de antibióticos também aumentou em 2024, quando estava prevista uma diminuição de 20%.
A resistência aos antimicrobianos ocorre quando bactérias, vírus, fungos e parasitas deixam de responder aos antibióticos e outros agentes, que se tornam ineficazes para o tratamento das infeções, aumentando o risco de propagação de doenças graves e de morte.
"O aumento da resistência antimicrobiana, juntamente com a escassez de novos tratamentos eficazes, constitui uma grave crise de saúde pública em evolução na Europa e no mundo", salientou ainda o comunicado.
Para a diretora da ECDC Pamela Rendi-Wagner, o combate à resistência antimicrobiana exige inovação em três frentes principais - "ações enérgicas" para o uso responsável de antibióticos, práticas sustentadas de prevenção e controlo de infeções e o desenvolvimento de novos antibióticos.
De acordo com o centro europeu, o aumento das infeções resistentes coloca em risco procedimentos que salvam vidas, como transplantes de órgãos, tratamentos contra o cancro, cirurgias e cuidados intensivos.
Alertou ainda que o desenvolvimento global de antibióticos continua a ser limitado, especialmente contra microrganismos prioritários para a saúde pública, como as bactérias resistentes aos carbapenemes.
"São necessárias soluções inovadoras para conter o aumento da resistência antimicrobiana, mas existem muito poucos novos antibióticos com mecanismos de ação inovadores perto da aprovação", realçou o ECDC.
A resistência antimicrobiana "não é apenas uma questão médica - é uma questão social. Devemos garantir que ninguém na Europa fica sem uma opção de tratamento eficaz", salientou Diamantis Plachouras, responsável dessa área específica no ECDC.
